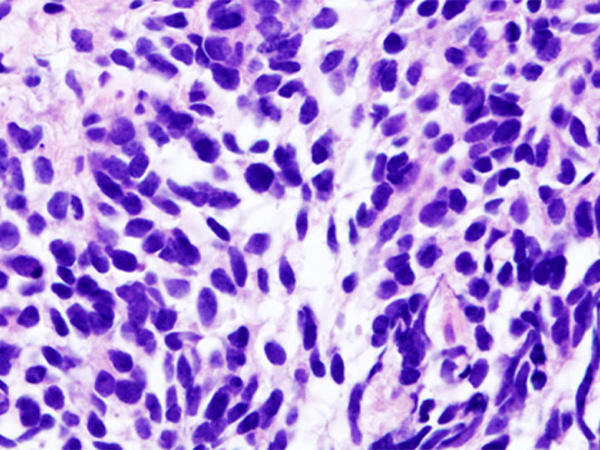

Increasing Immunotherapy Options for Lung Cancer Patients
The FDA has expanded the use of the immunotherapeutic pembrolizumab to treat certain patients with small cell lung cancer.
The U.S. Food and Drug Administration (FDA) recently approved expanding the use of pembrolizumab (Keytruda), a type of immunotherapeutic called a checkpoint inhibitor, to include the treatment of certain patients with small-cell lung cancer.
Specifically, pembrolizumab is intended for use in the treatment of metastatic small-cell lung cancer that has progressed after a patient has received platinum-based chemotherapy and at least one other treatment.
With this approval, pembrolizumab became the third checkpoint inhibitor approved by the FDA for use in the treatment of small-cell lung cancer. The first, nivolumab (Opdivo), was approved for treating metastatic small-cell lung cancer that has progressed after a patient has received platinum-based chemotherapy and at least one other treatment in August 2018. The second, atezolizumab (Tecentriq), was approved for use in combination with the cytotoxic chemotherapeutics carboplatin and etoposide for the initial treatment of adults diagnosed with extensive-stage small-cell lung cancer in March 2019.
Lung cancer is the second most commonly diagnosed cancer in the United States, with 228,150 new cases expected in 2019, according to data from the National Cancer Institute (NCI). There are two main types of lung cancer: non–small cell lung cancer (NSCLC), which accounts for up to 85 percent of lung cancers, and small cell lung cancer (SCLC), which accounts for up to 15 percent of cases.
According to the FDA, the agency based its approval of pembrolizumab for metastatic small-cell lung cancer on results from two clinical trials, one a phase I and the other a phase II. The combined results showed that pembrolizumab treatment led to partial or complete tumor shrinkage in 19 percent of patients whose disease had progressed after previous treatments. These responses lasted 12 or more months in 63 percent of the patients.
Before this approval, pembrolizumab had already been approved for treating certain patients with non–small cell lung cancer and 10 other types of cancer: bladder cancer, cervical cancer, head and neck cancer, Hodgkin lymphoma, kidney cancer, liver cancer, melanoma, Merkel cell carcinoma, non-Hodgkin lymphoma, and stomach cancer. It also had been approved for treating patients with any type of solid tumor that is characterized by the presence of specific biomarkers known as microsatellite instability–high or mismatch repair–deficient.